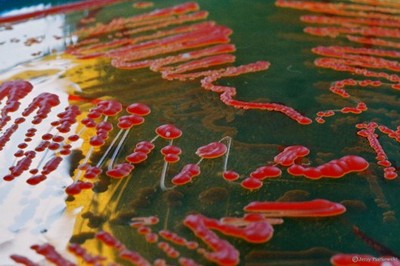
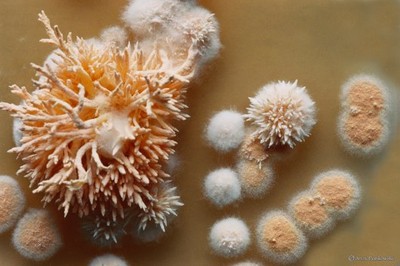

| Jerzy Piątkowski | Para-nauka i obok |
Grzyby owadobójcze
No i doigraliśmy się. Poziom para-nauki (a może paranauki, spór, jak być powinno, wciąż się odnawia) systematycznie rośnie. Sądzę, że za kilka lat dostaniemy się na Listę Filadelfijską, umieszczenie tekstu będzie poprzedzone wyrażeniem opinii przez dwóch recenzentów, a autor premiowany odpowiednią liczbą punktów za wywiązanie się z obowiązku publikowania.
Drogi Czytelniku, może nie uwierzysz, ale tekst ten został napisany przez doktora Jerzego Piątkowskiego specjalnie dla Fahrenheita. Jedną z pasji tego biologa są grzyby owadobójcze. Są takie; po lekturze odnoszę wrażenie, że jest ich bardzo wiele. Jeśli zapytasz, co ma to wspólnego z linią pisma: owszem, mamy elementy horroru. Uważny czytelnik, jeśli nie padnie na fachowej terminologii, która zresztą przeciętnemu posiadaczowi świadectwa maturalnego nie powinna być obca, znajdzie tu makabrę w najlepszym wydaniu, bo zupełnie prawdziwą. A poważniej, poszliśmy w opisywanie „jak działa ten świat”. Zapewne wiek XXI będzie wiekiem biotechnologii. Żeby się w tym wszystkim nie pogubić, trzeba wiedzieć, co to na przykład grzyby bakteriobójcze, albo choćby liznąć terminologii. Autorzy zaś znajdą małe co nieco dla siebie, elementy genetyki, fachowe słówka i zwroty. Artykuł wydaje się trudny, ale zachęcam. Na deser galeria fotografii, grzybów oczywiście. Jest to fragment wystawy, jaka była prezentowana we Wrocławskim Muzeum Archidiecezjalnym. Autorowi zdjęć, Jerzemu Piątkowskiemu, serdecznie dziękujemy za udostępnienie materiałów. Zapraszam do fantastycznego świata morderców owadów!
Adam Cebula
Występowanie grzybów owadobójczych
Jedną z form pasożytnictwa grzybów jest zakażanie owadów i wywoływanie u nich zmian chorobowych prowadzących często do śmierci. Występują one prawie we wszystkich klasach podziału systematycznego.
Najbardziej wyspecjalizowane w zabijaniu owadów występują w podgromadzie sprzężniowych Zygomycotina. Wszystkie gatunki należące do rzędu owadomorkowców Entomophthorales są pasożytami wewnętrznymi owadów, choć niektóre z nich mogą pasożytować w niższych bezkręgowcach, glonach, grzybach, roślinach naczyniowych. Niektóre mogą prowadzić w pewnych warunkach saprofityczny tryb życia, a więc żywią się martwymi szczątkami organicznymi. Można dodać, że pasożytowanie grzybów na innych grzybach nazywane jest nadpasożytnictwem. W omawianej podgromadzie grzybów sprzężniowych, w rzędzie Trichomycetales, występują wspomniane powyżej grzyby żyjące w symbiozie ze stawonogami w ich przewodzie pokarmowym. W rzędzie Mucorales zdolność do infekowania owadów szczególnie przez rany posiadają grzyby z rodzaju Mucor.
W kolejnej podgromadzie-workowców Ascomycotina występują patogeny pszczoły miodnej (Mycoderma cerevisiae) oraz innych pszczołowatych błonkówek Apidae. Patogeny te tworzą rodzinę Ascosphaeraceae w rzędzie kropidlakowców Eurotiales. Ascosphera apis może spowodować śmierć wszystkich pszczół w ulu. Zarodniki workowe rozmieszczone są w tym rzędzie workowców chaotycznie w kulistym owocniku zwanym klejstotecjum. Wśród workowców występują również mocno związane z owadami grzyby należące do owadorostowców Laboulbeniales. Są to zewnętrzne pasożyty (egzopasożyty) odznaczające się dużą specjalizacją w stosunku do żywiciela. Grzyby zakotwiczone są w oskórku jedną komórką, wystając na zewnątrz w formie kilku do kilkusetkomórkowych, a więc bardzo małych plech. Do tej grupy należą, np. grzyby z rodzaju Herpomyces – pasożyty karaluchów. Do egzopasożytów owadów należą również owady z rodzajów Aschersonia, Bettsia, Calonectria, Hypocrella, Cordyceps, Torubiella. Inny typ owocnika tworzą workowce z rzędu kulistych Sphaeriales. Owocnik ma tu kształt kuli, gruszki lub kolby, wewnątrz której worki ułożone są w sposób uporządkowany w warstwę zwaną hymenium i otoczone ścianą owocnika. W dojrzałym owocniku występuje otwór, przez który uwalniane są zarodniki workowe. Grzyby owadobójcze występują w rodzinie maczużnikowatych Cordycipitaceae w takich rodzajach, jak Cordyceps i Torubiella, które atakują głównie gąsienice i poczwarki motyli. Charakteryzują się one tym, że ze struktury przetrwalnikowej grzyba zwanej sklerocjum, utworzonej w ciele owada, wyrastają na zewnątrz przez otwór gębowy lub odbytowy maczugowate struktury, będące podstawkami owocników. Grzyby te występują przede wszystkim w obszarach tropikalnych i subtropikalnych.
W przypadku podstawczaków Basidiomycotina nie wykryto dotąd tak jednoznacznych patogenów, jak wymienione powyżej. Występują natomiast układy symbiontyczne, których ciekawym przykładem jest kolonia czerwców pokryta plechą grzyba z rzędu Septobasidiales. Grzyb chroni kolonię przed zwierzęcymi patogenami a pluskwiaki roznoszą zarodniki grzyba. Patogenicznie na owady działa muchomor, ale nie jest to typowa entomopatogeniczność, bowiem nie związana z pasożytnictwem lecz z toksycznym działaniem wydzielanych substancji – wtórnych metabolitów.
W ostatniej z wymienionych podgromad – Deuteromycotina zwanych grzybami niedoskonałymi lub mitosporowymi (tworzącymi zarodniki po mitotycznym podziale komórkowym, w odróżnieniu od zarodników po mejozie, który związany jest z rozmnażaniem płciowym i tworzeniem owocników) grzyby owadobójcze należą do rodzajów Beauveria, Paecilomyces, Verticillium, Hirsutella i in. Zdecydowana większość grzybów owadobójczych z tej podgromady należy do rzędu strzępczaków Hyphomycetales. Beauveria bassiana jest jednym z najczęściej występujących grzybów owadobójczych. Wraz z innym gatunkiem – Beauveria tenella tworzy charakterystyczny nalot zwany białą muskardyną (białe zarodniki na ciele zaatakowanych owadów). Atakuje w Polsce około 80 gatunków owadów: chrząszcze, motyle, różne stadia rozwojowe jedwabnika morwowego Bombyx mori, stonkę ziemniaczaną Leptinotarsa decemlineata, gąsienice owocówki jabłkóweczki. Metarrhizum anisopliae tworzący z kolei zieloną muskardynę, atakuje szarka komośnika Bothynoderes punctiventris – szkodnika lasów, jedwabnika, stonki ziemniaczanej, nałanka czarnego Anisoplia austriaca. Grzyb ten jest stosowany do zwalczania wymienionych szkodników. Sorosporella uvella, sprawca czerwonej muskardyny atakuje m.in. szarka komośnika i rolnicę zbożówkę. Paecilomyces fumosoroseus wywołujący różową muskardynę zabija m.in. owocówkę jabłkóweczkę i brudnicę nieparkę. Lecanicillum lecanii pasożytuje na różnych getunkach czerwców. Fusarium acridiorum rozwija się na oskórku szarańczy, lecz nie wnika do jamy ciała.
Rodzaje pasożytnictwa grzybów wobec owadów
Z punktu widzenia zakresu gatunków owadów atakowanych przez dany grzyb, intensywności zabijania owadów, przebiegu procesu infekcji oraz możliwości saprofitycznego trybu życia grzybów owadobójczych dokonywano prób podziału tych grzybów na poszczególne kategorie. Nie wnikając w ewolucję poglądów na ten temat na przestrzeni lat, można pokusić się wyodrębnienie pewnych grup grzybów w oparciu o przedstawione powyżej kryteria, mając na uwadze, iż ostatecznego doskonałego systemu w tym zakresie jeszcze nie stworzono.
Grzyby, tak jak inne organizmy żywe, różnią się pod względem jednych cech a z drugiej strony są podobne pod względem innych, co skłania do grupowania ich według różnych kryteriów i tworzenia użytecznych w praktyce, porządkujących systemów, z których najważniejszym jest obowiązujący aktualnie system taksonomiczny. Powyższe zdanie mówi o rzeczy oczywistej, nie jeden czytelnik uzna takie mądrości za zbyt oczywiste, banalne, aby warto byłoby je przedstawiać. A jednak ta oczywistość różnic i podobieństw między organizmami przesłania czasami inną prawdę, z której nie zawsze zdajemy sobie sprawę, a która jest bardzo istotna do interpretacji wszelkich podziałów taksonomicznych. Chodzi o to, iż na skutek ewolucyjnej łączności między organizmami występują formy pośrednie między wyodrębnianymi grupami organizmów. Każdy podział jest, więc, sztuczny. Grupując grzyby do poszczególnych kategorii według, np. kryterium pasożytnictwa, należy mieć świadomość istnienia form pośrednich między obligatoryjnymi pasożytami i obligatoryjnymi saprofitami. Problemy taksonomiczne nie wynikają tu z niezaradności badaczy, lecz z natury organizmów.
Według kryteriów przedstawionych na początku tego rozdziału można wyodrębnić wśród grzybów owadobójczych następujące grupy.
Monofagi. Atakują owady w zakresie jednego rodzaju lub rodzajów uważanych za bardzo blisko spokrewnione. Przykładem jest Zoophthora aphidis, która pasożytuje tylko na mszycach z rodzaju Anoecja żerujących na dereniach.
Oligofagi. Porażają tylko owady należące do jednego rzędu. Przykładem jest Enthomophthora muscae.
Polifagi. Mogą zarażać inne stawonogi, jak pająki i roztocze a nawet kręgowce, w tym człowieka. Wśród takich grzybów wymienić można Conidiobolus coronatus, Aspergillus vlavus, Beauveria bassiana.
Przedstawiony podział jest również niedoskonały, między innymi z omówionych wyżej względów. Klasyfikacje proponowane w tym względzie przez różnych autorów różnią się.
Nie ma ścisłej korelacji między przynależnością systematyczną grzybów a ich typem patogeniczności – fakultatywne pasożyty występują w różnych rzędach grzybów.
Przyczyny wybiórczości w atakowaniu owadów nie są dostatecznie rozpoznane. Trudno wytłumaczyć, dlaczego Zoophthora lipai zarażająca kilka gatunków z rodzajów Canthari, Rhagonycha i Maltinus jest obojętna wobec wielu gatunków spokrewnionych, z którymi w trakcie swego rozwoju ma częsty kontakt. Z drugiej strony Cordyceps entomorrhiza infekujący wśród owadów biegaczowatych tylko rodzaje Calosoma i Carabus nie atakuje innych spokrewnionych z tymi rodzajami owadów a zaraża o wiele mniej spokrewnione pluskwiaki z rodzaju Himacerus.
O pewnej wybiórczości, ale tym razem w podatności na zakażenia, można mówić również, jeśli chodzi o infekowane owady. Mszyce, które są atakowane przez wiele różnych grzybów, wykazują wyraźną odporność na Beauveria bassiana, który przecież, jako gatunek polifagiczny, ma szerokie spektrum zarażania; skoczogonki (Collembola) bardzo rzadko ulegają infekcji grzybowej przez jakikolwiek gatunek.
Tak, jak wszystkie inne cechy żywych organizmów, tak i pasożytnictwo grzybów na owadach jest skutkiem działania mechanizmów ewolucyjnych. W przypadku tego pasożytnictwa ewolucja, jak się wydaje, nadal zachodzi. Przyjmuje się, iż udoskonalenia w wykorzystywaniu ciała owadów jako środowiska, w którym grzyb może najskuteczniej zrealizować swoją biologiczną misję, idą w kierunku zwiększania specjalizacji grzyba w atakowaniu wąskiej grupy owadów; wydłużanie okresu, w którym owad jest zarażony, ale jeszcze żyje; zwiększenie infekcyjności w stosunku do owada, czyli skuteczności jego zarażania.
Ponieważ wszystkie grzyby należące do rzędu Entomophthorales są w większym lub mniejszym stopniu pasożytami owadów, należy uznać, iż pochodzą od wspólnego przodka, który wyspecjalizował się w tym procederze. Można je nazwać grzybami pierwotnie entomopatogennymi. Natomiast pasożytujące na owadach gatunki należące do workowców czy grzybów niedoskonałych (Deuteromycotina), wyspecjalizowały się wtórnie, w tym sensie, że ich najbliżsi przodkowie nie byli entomopatogenami.
Należy zatem uznać, iż cechy sprzyjające zabijaniu owadów, które posiadają współcześni przedstawiciele rzędu Entomophthorales, ewoluowały dłużej, niż analogiczne cechy występujące u grzybów reprezentujących inne taksony.
Owadomorki (Entomophtorales)
Jak wspomniano wyżej najbardziej wyspecjalizowaną i istotną grupą entomopatogenów są grzyby tworzące rząd owadomorków (Entomophtorales). Są one bardzo rozpowszechnione. Poszczególne rodzaje występują na wszystkich kontynentach i we wszystkich strefach klimatycznych. Wyjątek stanowi rodzaj Massospora, którego dotychczas wykryto tylko w Europie.
Owadomorki są głównie grzybami lądowymi, zasiedlającymi środowiska słabo przewiewne, zacienione i wilgotne, występujące w związku z tym w największej ilości w warstwie poszycia i runa leśnego lasów liściastych i mieszanych. Wymagania pod względem wilgotnosci są różne u poszczególnych gatunków. Są takie, jak Entomophaga kansana, Zoophthora aquatica, Zoophthora conica, które występują nad brzegami naturalnych zbiorników wodnych, a więc w środowisku o znacznie podwyższonej wilgotności. Ale są też gatunki wyraźnie sucholubne, jak Entomophthora muscae i Entomophaga aulice. Zdecydowana większość tych grzybów preferuje jednak dużą wilgotność, szczególnie w procesie infekowania owadów.
Wśród owadomorków występują obok gatunków pasożytniczych także saprofityczne żyjące w ściółce leśnej czy w powierzchniowej warstwie gleby (niektóre z rodzaju Conidiobolus). Formy pasożytnicze atakują zwykle stawonogi, głównie owady i pajęczaki, ale również nicienie i niesporczaki. Są również gatunki, które atakują rośliny (rodzaj Ancylistes i Completoria), a także wywołują efekt nadpasożytnictwa, tak, jak to jest w przypadku pewnego gatunku Conidiobolus, który żyje na owocnikach grzybów. Niektóre mogą spowodować również stan chorobowy (mikozę) zwierząt stałocieplnych w tym człowieka. Dotyczy to rodzaju Bassidiobolus i Conidiobolus.
Większość gatunków owadomorków charakteryzuje się wysoką specyficznością w stosunku do infekowanego gospodarza atakując jedynie kilka czy najwyżej kilkanaście gatunków. Największą specyficzność wykazują takie grzyby, jak Entomophthora grylli, która infekuje tylko szarańczaki, i Entomophthora erupta – tylko owady z rodziny Miridae. Specyficzność infekcji może dotyczyć nie tylko gatunku owada, ale również jego stadium rozwojowego. Zoophthora phytonomii zabija larwy i poczwarki ryjkowca lucerny Hypera postica a nie szkodzi osobnikom dorosłym. Z kolei Massospora cicadina atakuje imaginalne formy cykad a nie larwy. Larwy żyją bardzo długo, bo około siedemnastu lat, więc z pewnością dochodzi do ich kontaktu z zarodnikami grzyba, lecz nie do infekcji.
Owadomorki należą do klasy sprzężniaków, grzybów, których wspólną cechą jest sposób rozmnażania płciowego polegający na fuzji dwóch strzępek będących gametangiami należących do różnych typów płciowych,. Gametangia są strukturami, w których wytwarzane są haploidalne komórki pełniące rolę gamet, a łączenie się gametangiów jest jednym z typów procesu płciowego zwanym gametangiogamią. W wyniku gametangiogamii, w miejscu połączenia gametangiów powstaje charakterystyczna struktura, duża okrągła grubościenna komórka przetrwalnikowa zwana zygosporą, połączona z obu stron ze strzępkami obu „rodziców”. Do klasy sprzężniaków należą rzędy: Mucorales, Zoopagales oraz Entomophthorales. Przedstawiciele Entomophthorales różnią się od pozostałych dwóch rzędów posiadaniem ścian poprzecznych w strzępkach, przez co strzępki te podzielone są na jednojądrowe lub więcej niż jednojądrowe segmenty. Strzępki owadomorków, w porównaniu do występujących u grzybów należących do wielu innych rzędów, są stosunkowo grube, często tworzące bardzo nieregularne struktury. Gdy występują w ciele owada, rozpadają się często na niepołączone z plechą grzyba komórki zwane ciałami strzępkowymi. Ciała te mają różny kształt w zależności od rodzaju i gatunku grzyba. Mogą być prawie okrągłe, wydłużone, amebowate (kształt nieregularny), owalne. Może być wreszcie tak, iż u danego gatunku występują różne kształty ciał strzępkowych, czyli mamy do czynienia z polimorfizmem kształtu w ramach gatunku. U niektórych gatunków różnią się morfologicznie (wyglądem), bo pełnią różne funkcje, np. jedne są gametangiami, a z innych wyrastają trzonki konidialne. Tak jest u niektórych gatunków rodzaju Neozygites. Rozróżnia się dwa rodzaje ciał strzępkowych ze względu na ich powstawanie. Jedne są wynikiem rozpadu poszczególnych strzępek grzybni na grudki cytoplazmy, które nie posiadają ściany komórkowej, z jednym lub kilkoma jądrami komórkowymi w środku. Takie grudki zwane są protoplastami. Inne powstają po rozpadzie plechy grzyba na poszczególne, otoczone ścianą komórkową, komórki. Czasem w stosowanej nomenklaturze (nazewnictwie) ciałami strzępkowymi nazywa się tylko te formy, które posiadają ścianę komórkową odróżniając je w ten sposób od protoplastów.
Jak wspomniano powyżej, ciała strzępkowe mogą pełnić funkcję gametangiów. Wiadomo, iż konsekwencją istnienia gametangiów w klasie sprzężniaków, do których należą owadomorki, jest proces płciowy gametangiogami, w wyniku którego tworzy się zarodnik przetrwalnikowy – zygospora. Okazuje się, że formy przetrwalnikowe tworzone przez grzyby owadobójcze wewnątrz ciała owada są również zróżnicowane. Poza wspomnianymi zygosporami powstają u niektórych gatunków azygospory, nie różniące się morfologicznie od zygospor ale powstające z gametangiów apogamicznie, czyli nie na skutek połączenia (koniugacji) gametangiów. Jeśli dodamy do tego, iż mogą powstać formy przetrwalnikowe również z konidiów, u których nastąpiła modyfikacja (pogrubienie) ściany komórkowej; że mogą powstać formy zwane chlamydosporami, które są kulistymi lub owalnymi fragmentami strzępek wegetatywnych (a wi,ec ani spor ani gametangiów) z pogrubioną ścianą, to rysuje nam się coś, do czego zdążyliśmy się już przyzwyczaić, mianowicie kolejny obraz różnorodnych, złożonych i skomplikowanych form wytwarzanych przez grzyby owadobójcze. Trudno oprzeć się refleksji, iż ta złożoność form czyni zagadnienie grzybów owadobójczych trudnym, wymagającym dużej wiedzy i doświadczenia. Ale właśnie z tych powodów praca nad tymi organizmami jest niezwykle barwna, urozmaicona, fascynująca i dająca dużo satysfakcji.
W trakcie rozwoju owadomorków grzybnia rozwija się wewnątrz ciała owada w formie ciał strzępkowych czy protoplastów przeważnie wtedy, gdy owad jest jeszcze żywy. Gdy owad jest już martwy, następuje rozwój typowej grzybni strzępkowej, w której poszczególne komórki połączone są tworząc wymieszane ze sobą struktury niciowate.
Charakterystyczną cechą owadomorków jest zdolność do produkcji aktywnie odrzucanych komórek konidialnych. Są one wytwarzane na specjalnych wydłużonych strzępkach zwanych trzonkami konidialnymi, które mogą być nieodróżnialne od strzępek grzybni wegetatywnej, lecz na ogół różnią się one od niej morfologicznie grubością, kształtem czy rodzajem rozgałęzień. Właściwości fizjologiczne, morfologia i związane z tym zachowanie się komórek konidialnych jest jedną z najbardziej ciekawych, czy wręcz fascynujących, cech owadomorków, jako grzybów atakujących owady.
Trudno wyobrazić sobie bardziej wyrafinowany sposób dostosowania grzyba do atakowania owadów, jak „strzelanie” zarodnikami. Aktywne odrzucanie konidiów znacznie zwiększa zasięg rażenia owadów, zwłaszcza, gdy grzyb rozsiewający te zarodniki znajduje się w górnej części roślin, czy innych przedmiotów, wokół których przebywają docelowe owady. Można tu wyrazić wątpliwość, że zasięg oddziaływania zarodnikami byłby jeszcze większy, gdyby rozsiewanie one były tak jak zarodniki wielu innych grzybów – wiatropylnie. Należy mieć jednak na uwadze, że zarodniki owadomorków są znacznie większe od tych roznoszonych wiatrem, pokryte są lepką wydzieliną umożliwiającą przyklejanie do kutikuli owada. Wielkość tych zarodników wynika zapewne z faktu, iż po osiągnięciu celu muszą one wykonać bardziej skomplikowaną „pracę”, niż zarodniki wiatropylne. Zadaniem tych drugich jest jedynie wykiełkowanie na substracie, w którym ostatecznie się znalazły. Natomiast konidia owadomorków muszą wydzielić szereg enzymów trawiących oskórek owada, wytworzyć strzępkę kiełkującą i przerosnąć tą strzępką do wnętrza owada. Takie czynności wymagają znacznie więcej substancji zawartych w zarodniku niż u tych wiatropylnych. Zatem jedynym wyjściem, aby duży zarodnik miał odpowiednią siłę „rażenia” było wytworzenie mechanizmu wystrzelającego zarodniki.
Aktywne odrzucanie zarodników nie jest jedynym przystosowaniem do skutecznego zarażania owadów. Nie mniej fascynującym jest wytwarzanie tzw. zarodników wtórnych. Ewolucyjny nacisk selekcyjny na wytworzenie zarodników wtórnych powstał, prawdopodobnie, dlatego, iż podczas odstrzeliwania tych wspomnianych dużych konidiów wiele z nich nie osiągnęło celu, nie przykleiło się do kutikuli owada, lecz opadło na podłoże. Siła „rażenia zarodnika, po którym owady co najwyżej mogą deptać, jest prawie zerowa. Przecież zarodnik wtedy jest groźny, gdy przebije się do wnętrza ciała owada a nie jedynie przyklei do jego nogi. Krótko mówiąc, zarodnik leżący na podłożu jest z punktu widzenia swojej misji bezwartościowy, bo jest za nisko.
Ewolucja poradziła sobie z tym problemem w sposób równie wyrafinowany, jak wytworzenie mechanizmu odstrzelającego: leżące konidia pierwszego rzędu mają zdolność do wytworzenia...konidiów drugiego rzędu, tym razem umieszczonych na grubym lub cienkim stylisku, na tyle długim, że konidium może zarażać przechodzące owady na poziomie ich tułowia czy odwłoka.
Oczywiście w poszczególnych rodzinach owadomorków kształt i wielkość konidiów pierwotnych, wtórnych oraz stylisków, na których umieszczonych są konidia wtórne jest różny. Mogą być styliski grube, wówczas umieszczone na nich konidia wtórne nazywa się ballosporami, w odróżnieniu do stylisk cienkich z kapilisporami. Różnie też wyglądają komórki konidiotwórcze wytwarzające konidia pierwotne, które umieszczone są na trzonkach konidialnych.
Jeśli chodzi o mechanizm odrzucania konidiów, to aczkolwiek we wszystkich przypadkach oparty jest on na wzrastającym ciśnieniu osmotycznym w komórce zarodnikotwórczej i zarodniku, to wyróżnić można trzy zasadnicze mechanizmy różniące się w szczegółach. Komórka konidiotwórcza przylega do komórki konidialnej, gdy obie nie są zbyt napęczniałe. Pewien stopień wiotkości pozwala na istnienie połączenia między wypukłymi w rzeczywistości powierzchniami obu komórek tak, jak możliwe jest utrzymanie w połączeniu dwóch sklejonych na pewnej powierzchni, słabo napompowanych dziecięcych balonów. Łatwo sobie wyobrazić, iż gdy ciśnienie wewnątrz balonów wzrośnie wytworzą się siły rozrywające sklejenie. W przypadku wspomnianych komórek, ciśnienie w ich wnętrzu rosnie, gdy zwiększa się stężenie pewnych substancji, jak soli lub cukrów. Zwiąksza się tym samym tak zwana wartość osmotyczna wnętrza a wiec i ciśnienie osmotyczne. Wzrasta naprężenie ścian obu komórek i wielkość komórek. W przypadku większości grzybów owadobójczych następuje odrzucenie konidiów na skutek rozerwania otaczającej obie komórki oraz gwałtownego odszczepienia się ścian łączących te komórki. Innym mechanizmem jest oderwanie konidium wraz z częścią przylegającej ściany komórkowej komórki zarodnikotwórczej. W trzecim typie, konidium odrywa się wraz z zawartością komórki zarodnikotwórczej, ponieważ w momencie oderwania się konidium pęka górna część ściany tej komórki.
Plecha owadomorków rozwija się poprzez podział strzępek, czyli powstanie ściany poprzecznej wewnątrz komórki i powiększenie rozmiarów obu komórek potomnych, lub poprzez pączkowanie, które polega na uwypukleniu ściany komórkowej w pewnym miejscu, utworzeniu pączka, do którego przechodzi część materiału genetycznego komórki wraz z częścią cytoplazmy.
Podział systematyczny rzędu owadomorków na rodziny opiera się na liczbie jąder komórkowych w strzępkach i konidiach, wielkości tych jąder oraz intensywności ich wybarwiania się przez stosowane powszechnie w tym celu barwniki.
Zarodnik, który przykleił się do oskórka owada, wydziela enzymy rozpuszczające ten oskórek z wytworzeniem dziury, przez którą wrasta do wnętrza ciała owada strzępka infekcyjna. Rozpada się ona na pojedyncze komórki zwane ciałami strzępkowymi, które rozprzestrzeniają się po całym organizmie. Ciała strzępkowe wydzielają enzymy trawiące wnętrze owada prowadząc do powstania wypełniającą ciało owada mleczną substancję. Rozwijają się następnie wypełniając szczelnie wnętrze, co prowadzi do mumifikacji owada. W kolejnym etapie plecha grzyba wytrawia ponownie dziury w oskórku owada, tym razem od spodniej strony, przez które grzyb „wychodzi” na zewnątrz wytwarzając struktury zarodnikotwórcze, aktywnie odrzucane, umieszczone na długich strzępkach zwanych konidiami.
dr Jerzy Piątkowski
Instytut Genetyki i Mikrobiologii Uniwersytetu Wrocławskiego

W N U M E R Z E
| |
DZIAŁY STAŁE | |
| Okładka | 00 |
| Spis Treści | 01 |
| 451 Fahrenheita | 02 |
| Literatura | 03 |
| Bookiet | 04 |
| Recenzje | 05 |
| Spam(ientnika) | 09 |
| PMS | 10 |
| Galeria | 11 |
PUBLICYSTYKA | |
| Anna Misztak | 12 |
| Adam Cebula | 13 |
| M.Kałużyńska | 14 |
| W.Świdziniewski | 15 |
| Andrzej Zimniak | 16 |
PARA-NAUKA I OBOK | |
| Bartłomiej Czech | 17 |
| Dawid Juraszek | 18 |
| Adam Cebula | 19 |
| Jerzy Piątkowski | 20 |
LITERATURA | |
| Magdalena Kozak | 21 |
| Dušan Fabián | 22 |
| Jacek Izworski | 23 |
| Anna Głomb | 24 |
| Marek Kolenda | 25 |
ZAKUŻONA PLANETA | |
| Duo M | 26 |
| Hastatus | 27 |
EFEMERYDA | |
| awatar Wal Sadow | 28 |
NA CO WYDAĆ KASĘ | |
| Witold Jabłoński | 29 |
| Jaga Rydzewska | 30 |
| Wojciech Szyda | 31 |
|
| |






